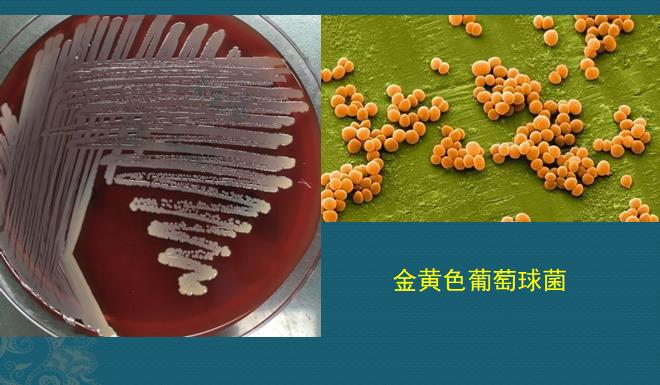
路边的野店不要去，花钱多，有些针还伤身体……

如果身体发生感染,不吃抗生素会怎么样?
很多人看问题片面,对抗生素有偏见,把它们看作洪水猛兽,这其实是不对的。地球上有很多微生物对人类并不善良,一不留神就会中招,引发严重感染,需要抗生素救命。
我们看一个17岁病人的CT片,外伤10天后发热、咳嗽就诊:

双肺多发炎症,密度增高
小伙子10天前小腿摔伤后感染了,红肿、发热发胀,没有及时、正规抗生素治疗,细菌在他小腿肌肉软组织里大量繁殖,并派出部队侵入血管,沿血液循环走到肺部,发现这里氧气充足、血流缓慢,非常适合繁殖,就放开了计划生育政策,以肉眼可见的速度快速繁衍,并制造大量毒素引发双肺炎症,表现为多发斑片状、磨玻璃密度影,边界不清。
这种细菌是化脓菌,化脓性感染速度很猛,5天后复查CT病灶进一步增多,并且把肺膜腐蚀破裂,肺泡腔里的气体漏出胸腔发生气胸(蓝箭头)和皮下气肿(红箭头),小伙子的胸部从外表看明显肿胀,压一下有捻头发的感觉,这是重症感染,有生命危险了。
这是什么细菌?为何破坏力这么强?
这个叫金黄色葡萄球菌,是细菌中的贪官佼佼者,像和珅一样狡猾,它每年都会引起很多起食物中毒,美国约33%的细菌性食物中毒都是它搞出来的;还能引起全身多处化脓性感染,包括化脓性肺炎,如果不及时治疗,会在短短几天内将肺脏烂出几个大空洞,有生命危险,治疗要花不少钱。
我们先看看它的真面目,把它们的痰液或者肺泡灌洗液涂抹到培养基上,37℃培养24小时,就会长成下面左图的样子:
左图是培养基,大量金黄色菌落
右图是它们在显微镜下的美颜艺术照,呈金黄色,像一串串葡萄,这个细菌在户口本上的名字,就叫金黄色葡萄球菌。
金黄色在古时候可是帝王之家专用,这个家伙敢穿这个颜色外套,确实有点和珅的本事:它耐热、耐盐、耐干燥,是抵抗力最强的无芽孢细菌。偏偏还在自然界中无所不在,空气、水、灰尘、人和动物的排泄物中都能找到,因而食品受污染的机会很多,食用后可以起中毒。大约30-50%的正常人的鼻腔和皮肤都存在金葡菌定植,并且可以跑到口腔、肠道、皮肤皱褶、腋窝等处。
为什么说它像和珅呢?
金葡菌侵入肺脏后是这样引起化脓性肺炎的:
1.先拉关系,用黏合蛋白贴附上细胞壁;
2.建保护伞 诱导宿主细胞重排骨架结构,像拉链一样包裹吞噬它,同时降低宿主免疫功能,逃避攻击,就像钻进了保护伞;
3.开始腐败 金葡菌会产生各种毒素,包括:凝固酶、核酸酶、溶血素、酚溶性调控蛋白、肠毒素、表皮剥脱毒素、中毒性休克征毒素等,用这些毒素开始欺负老实的肺细胞,吃拿卡要,中饱私囊;
4.金葡菌还能产生杀白细胞毒素,通过这种毒素对抗执法,欺负那些正义的免疫细胞;
5.等到机关算尽,恶贯满盈,引起嘉庆皇帝警觉,会被嘉庆赐一道白绫(抗生素),去天堂享福……

我们通过下面这个病例,看一下它贪、钻的特性:
下图是另一位病人,春节期间在家隔离,坐久了腰背痛,就到针灸推拿店做了针灸,结果几天后开始发高烧,考虑是皮肤消毒没做好,金葡菌沿着针孔侵入皮下筋膜和肌肉组织内,发生了右侧竖脊肌、髂腰肌和髋周脓肿,细菌还沿着血管入侵肺部,引起肺部金葡菌肺炎,小空洞形成:

图2有小空洞
这位病人后来做血液培养找到金黄色葡萄球菌,使用敏感抗生素治疗后好转,住院20多天,总算控制住感染好转出院了。
在这里奉劝大家,做针灸推拿、理疗等,尽量去正规医院,执行严格的消毒措施,避免意外感染。前几年有新闻报道,一位年轻姑娘结婚前去街边小店打耳朵眼,结果意外感染梅毒,后来家里闹得很不愉快,怀疑小姑娘的人品作风有问题……不过这几年都是使用一次性器械,只要规范操作,正确皮肤消毒(消毒液开瓶后要定期更换),这种风险几乎没有了。

发生金葡菌肺炎,肺部CT常见哪些表现?
如果不能早期及时治疗,这是一种致命性感染,所以了解金葡菌肺炎常见CT表现很重要!分为吸入性(原发性)感染和血源性(继发性)感染两种。
按照入侵金葡菌的毒力、侵入菌量、机体的免疫状态、治疗措施不同,可以呈现多种CT表现:
1.不小心吸入金葡菌颗粒之后,经常会在细支气管周围引发炎症反应(小叶性肺炎)。
我们上面说了,这种细菌繁殖很快,人体的37℃正好适合它繁殖,24小时内就能长出肉眼可见的菌落,所以细支气管周围炎会快速进展为小叶、亚段或肺段的实变区,呈融合的斑片状,支气管远端常不显示(脓液堵塞),约40%病人是双侧肺炎,累及下叶多见;此外还可见到液化坏死、空洞、气囊、大小不等的肺结节、肿块、气胸、脓胸(胸腔积脓)和脓气胸等;

2.可以表现为单一改变,也可以多种表现并存,并互相演变(细菌繁殖快速,可以随脓液流动播散);
3.吸入性金葡菌肺炎,常可见实变区内形成脓肿,以下肺叶多见,空洞在实变区中央,内壁光滑,外壁因为周围炎症而常常模糊,有时候空洞内脓液没有完全排空,可以气液平面。如下图,70岁女性,吸入性金葡菌感染:

咳嗽、发高烧住院,左上肺脓肿,2天后咳出大量脓稠痰液,复查CT出现空洞(病情变化快),对抗生素敏感,治疗12天后明显吸收好转。这种化脓性感染,只靠身体的自愈力是远远不够的。
4.血源性金葡菌感染,细菌就像野草种子一样,随血液到达肺部小血管周围生根发芽,制造毒素,多表现为多发点片状影或类圆形结节影,边缘清晰或模糊,沿支气管血管束或肺外周和基底部分布,因为是化脓性感染,多数结节最后会坏死、液化,形成空洞,当损伤血管或者形成血管内菌栓堵塞可以引起远侧肺组织缺血坏死(肺梗死),形成胸膜下楔形肺实变影:

血源性金葡菌感染不止会入侵肺部,还经常去血管丰富的关节、骨髓等,引起化脓性关节炎、骨髓炎、肝肾损害等,预后差,死亡率很高。
金葡菌肺炎能治吗?好治吗?
这个有敏感抗生素可以治疗,越早越好,不要让细菌繁殖太多造成重症感染。有些病人初诊不明确,医生甚至会在1-2天内,甚至24小时内复查x光片或者胸部CT,协助确诊,因为这个肺炎可以一日多变,进展很快。
葡萄球菌对青霉素G的耐药率高达90%左右,临床不作为首选;
青霉素耐药、苯唑西林敏感的葡萄球菌首选萘夫西林/苯唑西林,次选方案包括万古霉素和利奈唑胺;
对耐甲氧西林金黄色葡萄球菌肺炎(超级细菌)应收入单间病房,医护人员做好防护,推荐静脉应用万古霉素、去甲万古霉素、替考拉宁或利奈唑胺治疗。《肺部细菌感染临床与影像解析,张嵩》
都是些价格很贵的药……
所以,保护好自己的免疫力,多运动、勤洗手、少生病,健康就是最大的财富!

我是影像科豪大夫,分享小病例,传递正能量,欢迎关注!
#清风计划# #湖南医聊超能团#